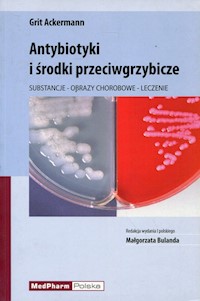
Antybiotyki i środki przeciwgrzybicze - Ackermann Grit - książka

Dostawa: od 6,99 zł (darmowa dostawa z abonamentem Legimi)
Czas wysyłki: 1-2 dni robocze + czas dostawy
Dostawa: od 6,99 zł (darmowa dostawa z abonamentem Legimi)
Czas wysyłki: 1-2 dni robocze + czas dostawy
Właściwe leczenie antybiotykami wymaga fachowej wiedzy i odpowiedniego doświadczenia, tak aby zastosowana terapia była skuteczna, niedroga i dobrze tolerowana przez pacjenta. Niniejsza książka obejmuje wiedzę z zakresu antybiotyków, leków przeciwgrzybiczych, jak i przeciwgruźliczych.
Znajdziemy tutaj dane na temat:
• farmakokinetyki i dawkowania leków, również u pacjentów z chorobami nerek
• schematy terapii zastępczej w różnych chorobach infekcyjnych
• zakres działania leków i profile oporności bakterii na antybiotyki
Książka jest doskonałą pomocą i uzupełnieniem aktualnej wiedzy zarówno dla praktykujących lekarzy, jak również studentów medycyny i farmaceutów.
Liczba stron: 594
Rok wydania: 2010
Format (wymiary): 15.5x23.0cm
ISBN: 9788360466902